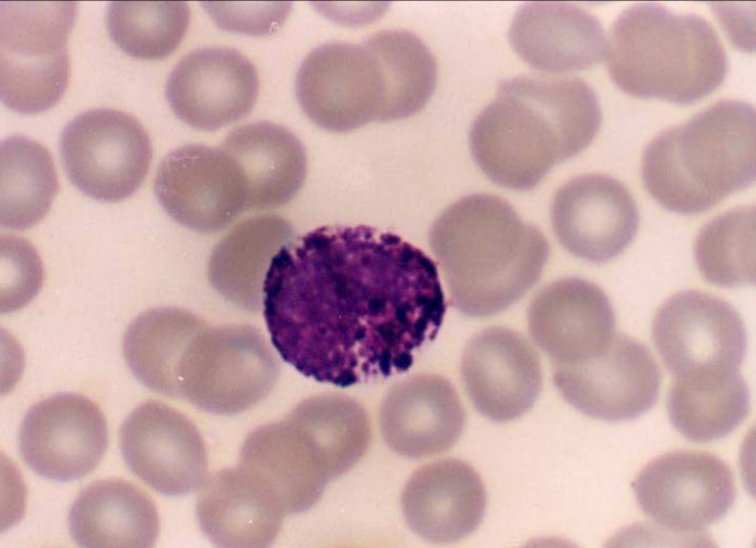

4.3.3 嗜碱性粒细胞
-
1 内容
-
2 测验
上一节
下一节
形态
● 细胞呈球形,直径 10-12μm。
● 核分叶,或呈S形或不规则形。
● 胞质内含有嗜碱性颗粒,大小不等,分布不均,染成蓝紫色,可覆盖在核上。
血细胞仿真图:

嗜碱性粒细胞光镜像(Wright-Giemsa,10×40):
嗜碱性粒细胞透射电镜像:

功能
● 嗜碱性颗粒(分泌颗粒),含有肝素、组胺、嗜酸性粒细胞趋化因子,细胞基质内有白三烯。
● 嗜碱性粒细胞与肥大细胞分泌的物质大致相同,也参与过敏反应。

